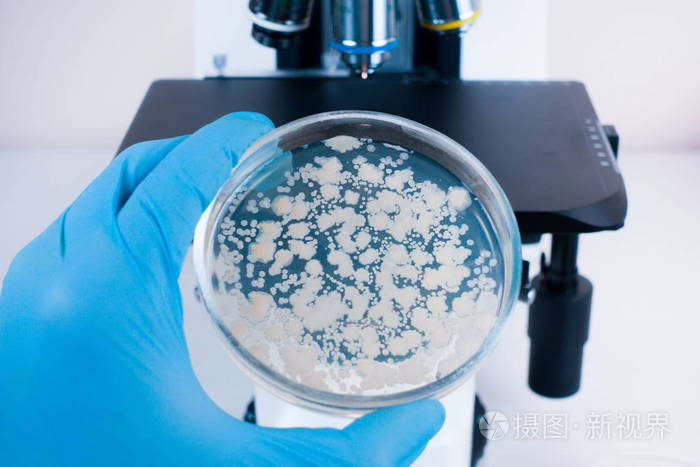
实验室显微镜和培养皿与细菌显微镜下细菌培养的分析显微镜下细菌的

细菌培养

细菌培养所需组分索引
图片尺寸598x447
自动计数培养皿中细菌菌落
图片尺寸1080x810
基因变异导致国际空间站出现"超级细菌"
图片尺寸623x480
戴着手套的手在培养皿中生长的细菌照片
图片尺寸450x300
实习#微生物室 细菌培养及鉴定,细菌涂片. - 抖音
图片尺寸886x1920
pca平板计数培养基上的,是细菌吗?
图片尺寸4032x3024
细菌,皮氏培养皿,大群动物,盘子,算命先生
图片尺寸1200x800
志贺氏菌显色培养基平板9cm培养皿科玛嘉原料细菌培养皿 十个2f包 十
图片尺寸800x800
微生物学细菌培养技术
图片尺寸1080x810
常用细菌培养基:肉汤培养基和普通琼脂培养基,lb培养液,tsb培养液
图片尺寸474x301
8】细菌,真菌观察培养——黑格尔老师带你开启微生物世界-在线订票
图片尺寸550x550
济南市中心医院病原微生物学实验室培养皿中的细菌
图片尺寸900x598
细菌培养照片
图片尺寸450x300
尿液细菌培养
图片尺寸3264x2448
通过本实验了解细菌分布的广泛性及细菌培养技术.
图片尺寸640x618
看到这些培养皿,真心疼自己,长得还不如细菌
图片尺寸592x574
血培养肉汤内细菌直接涂片与转种平板后形态差异
图片尺寸2560x1920
细菌培养
图片尺寸1200x800
细胞培养之细菌真菌的污染防治
图片尺寸1098x649
实验室显微镜和培养皿与细菌显微镜下细菌培养的分析显微镜下细菌的
图片尺寸700x467